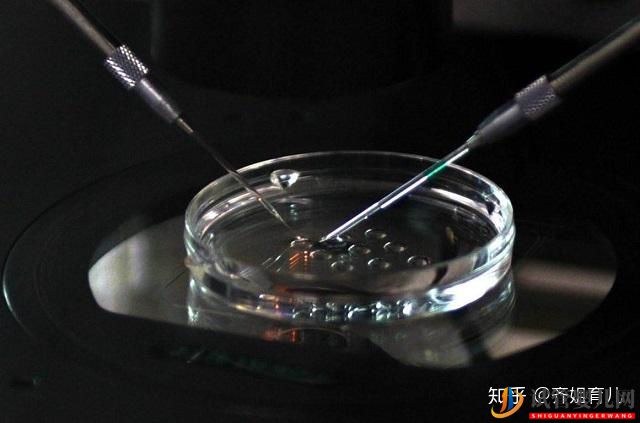
國內首例“試管嬰兒”,如今已32歲,生活狀況在眾人...(圖5)

?
日韩啪啪网站|
成人福利在线看|
一区二区三区在线观看www|
免费观看一二区视频网站|
亚洲美腿欧美偷拍|
在线免费看黄色片|
四虎国产精品成人免费影视|
欧美成人午夜剧场免费观看|
精品久久久无码中文字幕|
日韩综合在线视频|
国产成人精品免费看在线播放|
四虎精品在线|
欧美视频完全免费看|
一区视频免费观看|
日韩.com|
翡翠波斯猫1977年美国|
激情丁香婷婷|
精品久久久久久久久中文字幕|
国产免费一区二区三区网站免费|
www.豆豆成人网.com|
国产精品69av|
一个人看的www视频免费观看|
国产欧美日产一区|
免费观看一区二区三区|
韩国一区二区三区视频|
68精品久久久久久欧美
|
99久久久久免费精品国产|
男女无套免费视频网站动漫|
深夜av在线|
久久人体大胆视频|
一本大道一区二区三区|
99re8在线精品视频免费播放|
中文字幕国产传媒|
中文.日本.精品|
久久久久亚洲精品国产|
欧美性受xxxx黑人爽|
国产调教视频一区|
青青草视频网站|
红杏成人性视频免费看|
91久久久久久久久久久|
亚州av影院|
色综合天天视频在线观看|
美女福利视频在线观看|
欧美成人有码|
日韩一区二区三区高清|
av中文在线|
精品亚洲夜色av98在线观看|
亚洲国产精品欧美久久|
国产一区二区久久|
五月婷婷深爱五月|
亚洲影视资源|
国产精品免费久久久|
www.麻豆av.com|
一本色道久久综合精品竹菊|
精品无码人妻一区二区三区品|
在线欧美亚洲|
97碰在线视频|
中文字幕乱码在线播放|
午夜剧场成人观在线视频免费观看
|
国产成人综合在线|
亚洲理论中文字幕|
亚洲一区二区三区在线免费
|
在线观看免费av片|
免费人成黄页网站在线一区二区|
99精品在线免费视频|
小早川怜子影音先锋在线观看|
欧美俄罗斯性视频|
色网在线播放|
欧美性xxxx在线播放|
日韩在线视频免费播放|
奇米色777欧美一区二区|
日韩欧美xxxx|
精品视频在线播放一区二区三区|
国产在线播放91|
黄页大全在线免费观看|
精品久久久三级丝袜|
亚洲精品一区二区三区四区
|
欧美另类色图|
亚洲国产美女搞黄色|
国产精品99精品无码视|
日韩精品成人一区二区在线|
www.超碰com|
亚洲视频三区|
国产精品加勒比|
91社区在线|
久久久www成人免费精品张筱雨|
国产麻豆免费|
激情懂色av一区av二区av|
少妇一级淫片免费放中国
|
粗大黑人巨茎大战欧美成人|
精品中文字幕乱|
免费看涩涩视频软件|
91福利在线免费观看|
91九色蝌蚪91por成人|
9久草视频在线视频精品|
www.色天使|
国产精品a级|
男人天堂999|
日韩中文字幕无砖|
久99久在线|
欧美bbbxxxxx|
欧洲成人在线观看|
91短视频在线|
日韩国产激情在线|
狂野欧美激情性xxxx|
欧美日韩在线观看视频|
亚洲视频一区在线播放|
久久亚洲精品小早川怜子|
91禁男男在线观看|
久久精品一本|
日本中文字幕在线不卡|
日韩三级在线|
男女啪啪免费视频网站|
欧美影院在线|
欧美日韩精品久久|
日本在线高清|
成人a免费视频|
成年女人的天堂在线|
欧美福利小视频|
国产农村av|
亚洲色图美腿丝袜|
十大免费污污软件|
欧美一级一级性生活免费录像|
亚洲 欧美 精品|
婷婷综合另类小说色区|
亚洲自拍偷拍另类|
国产精品国模大尺度视频|
日韩污视频在线观看|
成人午夜激情在线|
www.com.av|
久久成人精品无人区|
亚洲第一黄色网址|
一区二区久久|
91亚洲一区二区|
国产高清一区二区|
国产av人人夜夜澡人人爽|
国产中文精品久高清在线不|
成人网站免费观看入口|
成人搞黄视频|
亚洲国产精品女人|
日韩激情综合|
国产精品av免费|
精品国产一区二区三区性色av|
欧洲久久久久久|
超碰这里只有精品|
欧美大陆一区二区|
yiren22亚洲综合|
欧美精品一区三区在线观看|
校园春色亚洲色图|
久久一区二区三区欧美亚洲|
综合另类专区|
国产呦系列欧美呦日韩呦|
国产一二在线播放|
国产精品一区而去|
亚洲性受xxx喷奶水|
国产九色91|
天天免费亚洲黑人免费|
精品欧美一区二区精品久久|
午夜精品成人av|
开心色怡人综合网站|
久久xxx视频|
日韩hmxxxx|
爱情电影网av一区二区|
亚洲精品在线观看免费|
午夜久久av|
丁香六月激情网|
国产亚洲欧美日韩在线观看一区二区
|
欧美日韩国产综合一区二区|
四虎精品影院在线观看视频|
6080国产精品一区二区|
国产日韩欧美一区二区三区视频|
日韩一级大片在线|
日本www视频|
国产亚洲欧美另类中文|
免费观看羞羞视频网站|
久久久久久久一区二区三区|
黄色免费在线播放|
国产精品免费一区|
av免费不卡|
久久精品五月婷婷|
国产色99精品9i|
欧美极品少妇无套实战|
精品久久久久久久久久久aⅴ|
精品国产成人av在线免|
欧美在线视屏|
欧美xxxxx精品|
麻豆一区二区99久久久久|
99国产精品无码|
777视频在线|
一二三区在线观看|
韩国国内大量揄拍精品视频|
成人av毛片|
91在线高清免费观看|
欧美裸体视频|
色噜噜一区二区|
国产成人一二|
国产成人久久777777|
午夜精彩国产免费不卡不顿大片|
亚洲成a人无码|
久久成人免费网站|
香蕉视频一区二区|
亚洲欧美另类在线|
无码精品一区二区三区在线|
91精品国模一区二区三区|
奇米影视狠狠狠|
精品国产欧美一区二区三区成人|
青草久久伊人|
91老司机精品视频|
国产福利一区二区三区在线播放|
国产香蕉一区二区三区|
欧美日韩伦理|
国产精品99久久久精品无码|
久久99国内精品|
国产成人亚洲欧洲在线|
一区二区三区国产豹纹内裤在线|
极品美女一区二区三区视频|
精品国产一区二区三区久久久蜜月|
另类图片亚洲色图|
欧美在线激情视频|
理论片午夜视频在线观看|
伊人久久av导航|
日韩欧美综合|
中文字幕在线观看的网站|
heyzo一本久久综合|
国产一区二区三区成人|
欧美日韩亚洲综合|
天天综合天天操|
欧美亚洲伦理www|
蜜桃视频在线观看播放|
美国av在线播放|
一个色综合网|
亚洲图片另类小说|
欧美激情一区二区三区在线|
手机看片1024国产|
日韩成人在线视频|
四虎影院在线播放|
97免费资源站|
av毛片精品|
一级网站在线观看|
国产福利精品导航|
91tv国产成人福利|
欧美一级片在线观看|
天堂视频福利|
91在线精品视频|
亚洲成人五区|
欧美专区第二页|
成人永久免费视频|
www.com欧美|
亚洲国产小视频|
免费在线稳定资源站|
韩国一区二区三区美女美女秀
|
欧美行性性性o00x|
欧美成人高清视频|
俺来也官网欧美久久精品|
51xx午夜影福利|
亚洲日本久久|
国产污视频在线看|
色香蕉久久蜜桃|
男女午夜网站|
91视频国产精品|
美女av一区|
无码精品一区二区三区在线播放|
久久久久久久网|
九九久久久2|
久久视频这里只有精品|
6699嫩草久久久精品影院|
97超碰国产精品|
久久看片网站|
这里只有精品免费视频|
日韩午夜小视频|
污视频在线观看免费|
久久一区二区精品|
久久久久久久久99精品大|
中国一级片在线观看|
午夜电影一区二区三区|
2色视频网站|
国产日韩精品视频|
欧美亚洲大陆|
永久免费成人代码|
亚洲在线观看免费视频|
狠狠操五月天|
国产在线精品一区免费香蕉
|
久久亚洲国产精品尤物|
中文字幕亚洲影院|
91麻豆蜜桃一区二区三区|
狠狠色综合久久婷婷|
欧美极品少妇与黑人|
99久久er|
91视频免费入口|
国产农村妇女毛片精品久久麻豆
|
亚洲女同一区|
精品午夜福利视频|
3atv一区二区三区|
久久精品色图|
在线一区亚洲|
日韩1区2区日韩1区2区|
国产美女裸体无遮挡免费视频|
国产视频精品va久久久久久|
亚洲夜夜综合|
91黄色小网站|
成人av在线播放网站|
亚洲国产成人综合|
欧美一级大片在线观看|
julia中文字幕一区二区99在线|
久久精品国产亚洲av久|
亚洲成人一区二区在线观看|
国产成人午夜电影|
久久综合中文色婷婷|
亚洲黄色毛片|
亚洲一区在线观|
亚洲一二在线观看|
欧美二三四区|
美女网站视频在线观看|
亚洲欧美一区二区三区极速播放|
jizz中国免费|
国产一区在线免费观看|
亚洲手机视频|
一区不卡在线观看|
中文字幕精品一区久久久久|
三上悠亚国产精品一区二区三区|
亚洲综合在线一区二区|
中文字幕日韩av资源站|
天天干天天爽|
欧美另类网站|
久久一区亚洲|
日本xxxxwww|
97高清免费视频|
久久综合社区|
欧美被狂躁喷白浆精品|
欧美一区二区三区喷汁尤物|
国产黄色在线网站|
无码人妻精品一区二区三区66|
久久久高清一区二区三区|
六月天色婷婷|
久久99国产精品99久久|
麻豆久久精品|
亚洲va在线va天堂成人|
日韩视频一区二区三区|
黄网站在线免费|
国产又大又黄又粗又爽|
国产精品欧美一级免费|
亚洲四虎av|
天天爽天天狠久久久|
精品在线播放午夜|
欧美性free免费|
91麻豆桃色免费看|
欧美日韩国产一区精品一区|
国产一区二区麻豆|
欧美激情乱人伦|
麻豆一区一区三区四区|
亚洲精品午夜久久久久久久|
日韩高清a**址|
欧美与亚洲与日本直播|
久久成人激情视频|
欧美日产国产精品|
人人超在线公开视频|
日本一区二区三区在线免费观看|
一区二区三区自拍|
性色av一区|
六月丁香婷婷激情|
国产精品乱码一区二区三区软件|
三级黄色网址|
中文字幕日韩精品无码内射|
97久久久精品综合88久久|
免费看的av|
一区二区三区的久久的视频|
国产成人av影院|
特大巨黑人吊性xxxxn38|
乱一区二区三区在线播放|
免费xxxx性欧美18vr|
欧美国产中文|
国产精品一区而去|
另类人妖一区二区av|
国产精品视频一区麻豆|
国产一区福利视频|
精品一二三四区|
在线观看黄网站免费继续|
欧美主播一区二区三区美女 久久精品人|
免费高清成人在线|
国产成人精品实拍在线|
美女一区视频|
国产高清在线精品|
成网站在线观看人免费|
亚洲一区二区三区精品动漫|
成人av网在线|
婷婷色播视频|
精品国产av无码一区二区三区|
国产女人aaa级久久久级|
在线视频专区|
嫩草av久久伊人妇女超级a|
亚洲成在线观看|
黄视频网站在线|
中文文字幕文字幕高清|
欧美顶级少妇做爰|
色豆豆成人网|
欧美成人精品一区二区免费看片
|
欧洲亚洲两性|
国产美女久久久久久|
亚洲三级黄色在线观看|
久久综合社区|



 二、改善基因缺陷以前卵子與受精卵的結合是隨機的,現在第三代“試管嬰兒”技術可以從父親體內挑選最健康的精子,并與母親體內的優質卵子結合。
二、改善基因缺陷以前卵子與受精卵的結合是隨機的,現在第三代“試管嬰兒”技術可以從父親體內挑選最健康的精子,并與母親體內的優質卵子結合。 三、提高不能生育女性的地位
三、提高不能生育女性的地位







